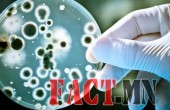
бактер

Халдвар авсан иргэдийн нэрийг зарласан албан тушаалтнуудад сахилгын шийтгэл оногдуулжээ
С.САРУУЛ
Хөвсгөл аймгийн Эрдэнэбулган сумын онцгой комиссын шийдвэрээр коронавирусын халдвар авсан иргэдийн нэрсийг сумын фэйсбүүк хуудсаар олон нийтэд мэдээллэсэн, Түнэл суманд коронавирусын халдвар авсан иргэдийн байршлыг олон нийтэд зарлаж, ойр орчимд зорчихгүй байхыг нийтэд анхааруулах зэргээр халдвар авсан иргэдийг ялгаварлан гадуурхаж, нэр төрд халдсан талаар мэдээлэл ХЭҮК-т ирсний дагуу шалгах үйл
- Categories: Муухай монголчууд (4), Мэдээлэл